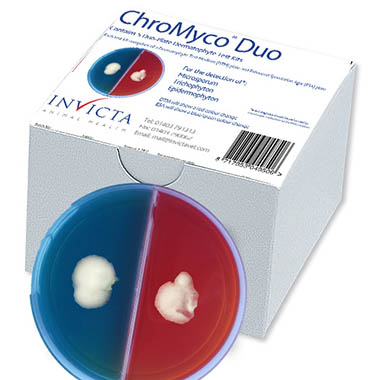
Pack shot of new ChroMyco Duo

Invicta Animal Health Launches Enhanced Version Of The Popular ChroMyco® Duo Dermatophyte Test
 12 years ago
12 years ago  4645 views
4645 views
Posted
9th November, 2014 19h43
Invicta Animal Health has launched an enhanced version of the popular ChroMyco® Duo dermatophyte test.
The tests utilise a new round plate with improved lid design. Additionally the plates are wider and deeper providing 25% more culture medium.
The dual plate test with Dermatophyte Test Media (DTM) on one side and an Enhanced Sporulation Agar (ESA) on the other greatly reduces the risk of false positive results. The test is performed by veterinary staff taking a pluck of fur or skin scrape from the lesion and inoculating both sides. After three to six days of room temperature incubation, if dermatophytes are present, the DTM will turn red and the ESA will turn blue-green.
Commenting on the launch of the new ChroMyco®Duo, Rob Watkins, Managing Director of Invicta, said: “We always listen and respond to customer feedback. The new design plates provide reduced condensation levels and by being easier to inoculate will enhance the usability and hence reliability of the test. ”
The price remains unchanged at just £32.00 for 5 tests and are available in veterinary wholesalers.
For further information on ChroMyco®Duo or Invicta, please contact the company on 01403 791313 or email them at [email protected].
Invicta Animal Health has launched an enhanced version of the popular ChroMyco® Duo dermatophyte test.
The tests utilise a new round plate with improved lid design. Additionally the plates are wider and deeper providing 25% more culture medium.
The dual plate test with Dermatophyte Test Media (DTM) on one side and an Enhanced Sporulation Agar (ESA) on the other greatly reduces the risk of false positive results. The test is performed by veterinary staff taking a pluck of fur or skin scrape from the lesion and inoculating both sides. After three to six days of room temperature incubation, if dermatophytes are present, the DTM will turn red and the ESA will turn blue-green.
Commenting on the launch of the new ChroMyco®Duo, Rob Watkins, Managing Director of Invicta, said: “We always listen and respond to customer feedback. The new design plates provide reduced condensation levels and by being easier to inoculate will enhance the usability and hence reliability of the test. ”
The price remains unchanged at just £32.00 for 5 tests and are available in veterinary wholesalers.
For further information on ChroMyco®Duo or Invicta, please contact the company on 01403 791313 or email them at [email protected].More from
- Cancellations have been damaging locum work for years but no-one was keeping count - now Ronda is
- Vet-founded charity looking to support talented youngsters
- Virbac Confirms Immediate UK Availability of Syvazul BTV 8 Vaccine for Livestock Protection
- Oxford veterinary practice unleashes its full potential with major expansion to celebrate 20th anniversary
- Crufts volunteer vet team donates £1,000 to ProSalus Foundation appeal to support Ukrainian veterinarians


 13 hours ago
13 hours ago